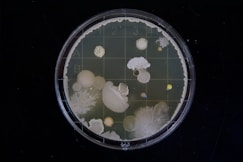

St. Charles Mold Removal Services Locals Rely the Most!
Welcome to St. Charles Mold Removal Experts


Are you facing the relentless battle against mold in your St. Charles home or business? Don't let mold take over your property and your peace of mind. We are the St. Charles mold removal experts, who are your local mold removal specialists dedicated to providing top-notch mold remediation services in St. Charles, Missouri, and the surrounding areas. With years of experience and a commitment to excellence, we are here to help you breathe easier and live healthier by eradicating mold problems from your property.

Our Services
Comprehensive Mold Removal and Remediation in St. Charles:
Mold can be a hidden menace, lurking behind walls, ceilings, or within damp corners of your property. We specialize in comprehensive mold removal services that not only address visible mold but also hidden sources. Our team of certified technicians employs cutting-edge technology and proven techniques to identify and eliminate mold growth at its source. When you choose us, you're choosing a mold-free future for your property.
Safe and Effective Mold Remediation:
Mold removal is a complex process that requires expertise and precision. Our mold remediation specialists are trained to handle mold infestations of all sizes safely and effectively. We follow industry best practices and use eco-friendly methods to ensure your property is not only mold-free but also safe for you, your family, or your employees.
Preventive Measures:
We believe that prevention is the best defense against mold. Our experts will not only remove the existing mold but also provide guidance on how to prevent future infestations. We'll identify and address moisture issues, improve ventilation, and recommend maintenance practices to keep mold at bay.
Mold Inspection and Testing:
Our mold inspection and testing services are the first steps in ensuring your property is mold-free. We use state-of-the-art equipment to identify and assess mold growth accurately. Our experienced technicians will provide you with a detailed report, outlining the extent of the mold issue and the necessary steps to remediate it effectively. Your health and safety are our top priorities.


Why Choose Us?
Experienced Professionals:
Our team consists of certified mold removal experts with years of experience in the field. We understand the unique challenges that St. Charles residents face when it comes to mold, and we have the knowledge and expertise to address them effectively.
Advanced Technology:
We invest in the latest mold detection and removal technology to ensure that we can provide you with the best service possible. Our advanced equipment allows us to identify and eliminate mold with precision.

Local Expertise:
As a locally owned and operated business, we are deeply committed to the St. Charles community. We understand the specific mold issues that residents in this area face and tailor our services accordingly.


Customer-Centric Approach:
Ensuring your complete satisfaction is our foremost commitment. We work closely with our clients to understand their needs and concerns, and we provide transparent, honest, and affordable solutions.
Eco-Friendly Solutions:
We care about the environment as much as we care about your property. That's why we use eco-friendly mold removal techniques that are safe for you, your family, and the planet.
Contact Us
Ready to take the first step towards a mold-free property? Contact us today for a free consultation and estimate. We're here to answer your questions, address your concerns, and provide you with the peace of mind you deserve. When it comes to mold removal in St. Charles, we are the experts you can trust.

Testimonials
"These mold removal experts saved our home. We had a severe mold issue that we didn't even know about until we called them for an inspection. They were thorough, professional, and incredibly efficient. We couldn't be happier with the results."
- Sarah P.
"I can't thank you enough. They not only removed the mold from my basement but also gave me valuable advice on preventing future issues. They truly go above and beyond."
- John M.

Stay Informed, Stay Mold-Free
Stay up-to-date with the latest news, tips, and information about mold removal and prevention in St. Charles. Our blog is a valuable resource for homeowners and business owners looking to protect their properties and their health.
Service Areas
We proudly serve St. Charles, Missouri, and the surrounding areas. If you're in need of mold removal and remediation services in these areas, don't hesitate to reach out to us.
Connect With Us
Follow us to stay updated on the latest news, tips, and promotions from the most trusted mold removal experts in St. Charles, MO. We're here to connect with our community and provide valuable information to help you maintain a mold-free property.
Choosing us means choosing a healthier, safer, and mold-free future for your home or business. Contact us today and let us help you take back control of your property.



Contacts
Address
hello@stcharlesmoldremoval.com
636-238-7891
Proudly Serving the St. Charles, Missouri, 63301 Area!
This site is a free referral service to assist homeowners in connecting with local service contractors. All contractors are independent and this site does not warrant or guarantee any work performed. It is the responsibility of the homeowner to verify that the hired contractor furnishes the necessary license and insurance required for the work being performed. Some reviews listed either on this website or on 3rd party listings are paid reviews or posted by associates of the company. All persons depicted in a photo or video are actors or models and not contractors listed on this site.
